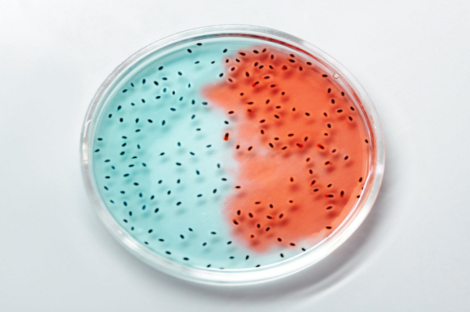

تايواني يتزوج 4 مرات خلال 37 يوما للحصول على إجازات مدفوعة الأجر
تفتق ذهن موظف في تايوان عن خطة لتمديد إجازة زواجه مدفوعة الأجر 4 مرات متتالية. وبحسب قانون العمل في تايوان…

تفتق ذهن موظف في تايوان عن خطة لتمديد إجازة زواجه مدفوعة الأجر 4 مرات متتالية. وبحسب قانون العمل في تايوان…

مُرشح للانتخابات البرلمانية في المكسيك، أطلق حملته الانتخابية، بطريقة غريبة، حيث بدأ بالترويج لبرنامجه الانتخابي من داخل نعش. وأفاد كارلوس…

أطباء في تايلاند تمكنو مؤخرا، من تخليص رجل كان يعاني من أوجاع في منطقة البطن، من أكبر دودة شريطية سجلت…

صحيفة “ديلي ستار” البريطانية نشرت ان جرذا من نوع “هامستر” يُدعى ستالين أنقد صاحبته أندريا لانغ البالغة من العمر 43…

شهدت ولاية أوكلاهوما الأمريكية جريمة مروعة في، حيث قالت السلطات أن لورانس أندرسون قام بطعن جارته لين بلانكشيب البالغة من…

بسبب حالة طبية نادرة يعمل الأطباء بشكل حساس لحل حالة طبية فريدة من نوعها، يعاني منها طفل لا يتجاوز 3…

شهدت، اليوم الأحد، العاصمة اليابانية طوكيو أحد طقوس ديانة شينتو، وهو النزول إلى حمام مياه مثلجة طلبا لنقاء الروح والصلاة…

صائغ من حيدر أباد حقق رقما قياسيا عالميا بصنع خاتم مرصع بأكبر عدد من الماسات على الإطلاق، قارب 8 آلاف…

بلدة جميلة في صقلية أصبحت هي الأحدث في الاتجاه المتزايد في إيطاليا ببيع منازلها المهجورة بالمزاد مقابل 1 يورو لكل…

اعتُبرت الثعابين ذات الرأسين عند بعض الشعوب على أنها أصنام في الأساطير القديمة، ولكن المخلوق النادر رُصد مؤخرا في عالمنا…

فراشة الشريط الأزرق مدرجة في الكتاب الأحمر لأوكرانيا كنوع معرض للخطر. حيث اكتشف موظفو القسم العلمي في محمية تشرنوبل للإشعاع…

صرحت الشرطة الصينية، إن مخطوطا يحتوي خط مؤسس الصين الحديثة ماو تسي تونغ، تقدر قيمته بمئات ملايين الدولارات، قد تعرض…
يمكن للكتلة الحيوية الفيروسية التي تغمر مناظرنا الطبيعية، وتنجرف عبر الغلاف الجوي وتطفو في محيطاتنا، أن تضيف نحو عشرات الملايين…

أزمة هوية.. سلوك نعامة يثير استغراب عاملين بحديقة حيوانات. أثار سلوك ذكر نعامة استغراب العاملين في “لينغليت سفاري بارك” ببريطانيا،…